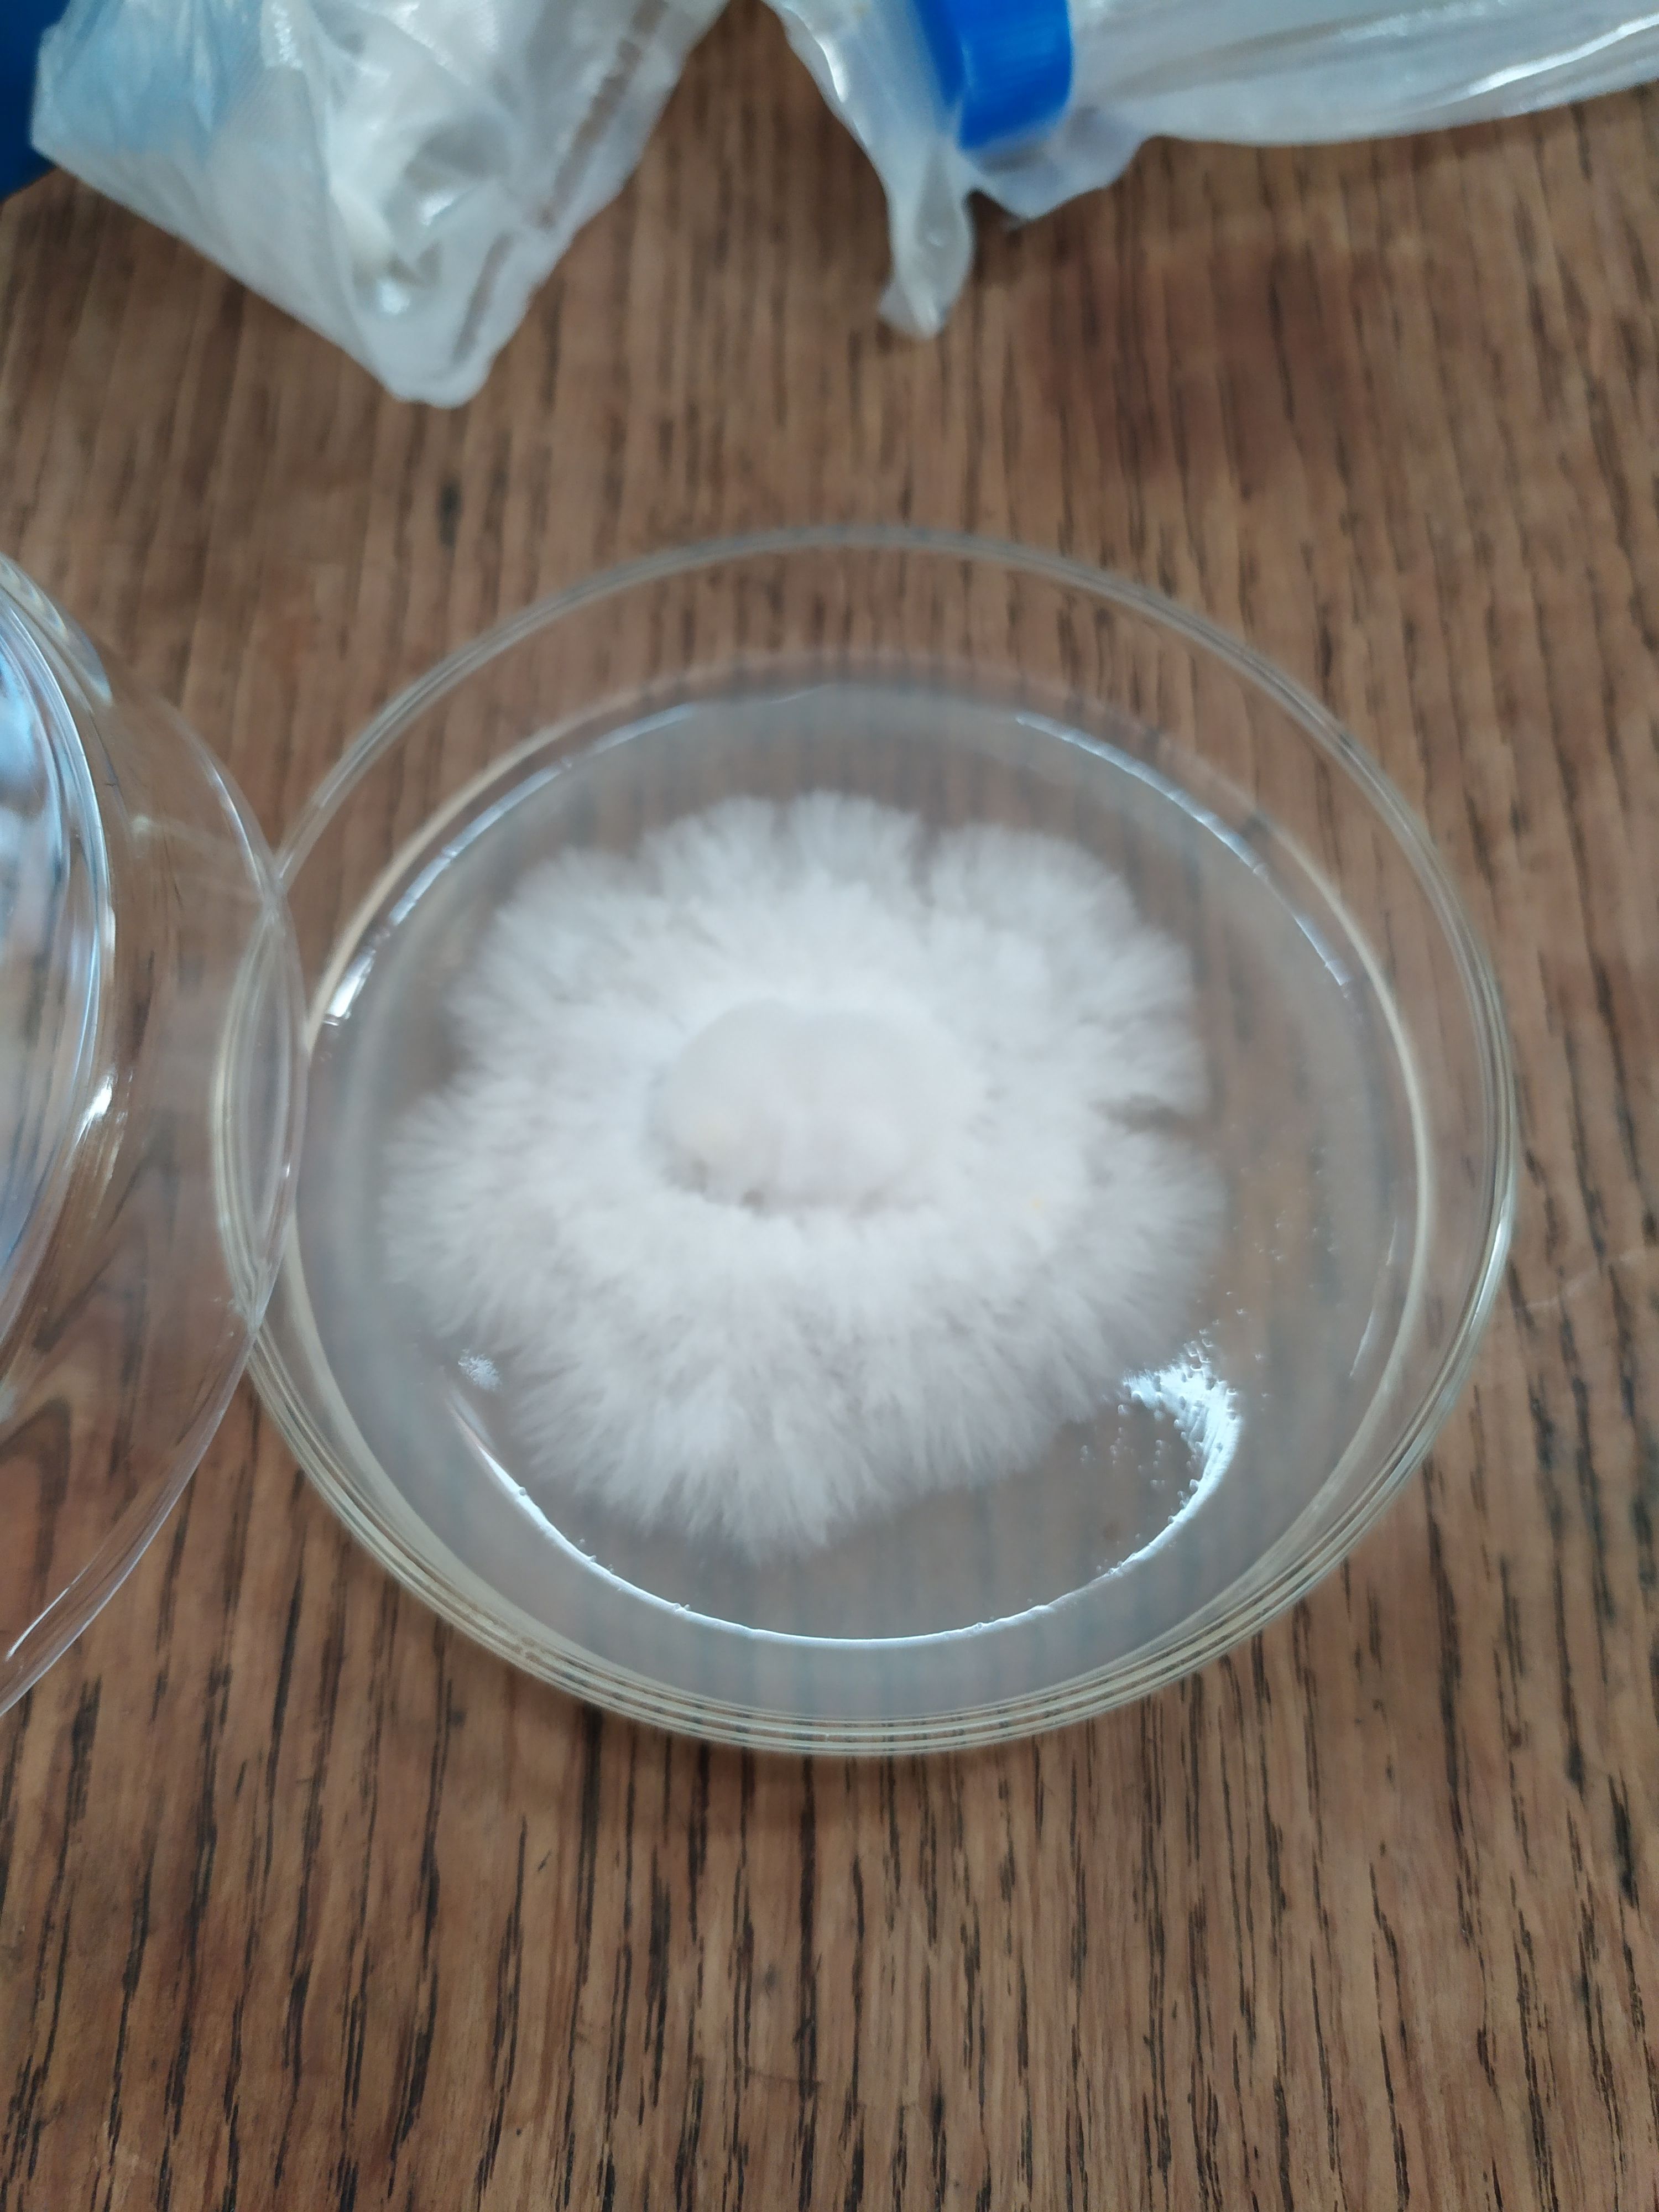

With a group of 5 friends we started “Fermentation station”.
We get a part of storage shed do all our fermentation projects.
Like beer, cheeses, dry aged meat, sausages, soy sauce, garums etc...
For this we repurposed old fridges as climate control cabinets.
For the simple fermentation chamber with only temperature control, no humidity control.
I used BrewPi, see here for build instructions.
It’s a raspberry Pi that controls different Arduinos that controls fridge and heating.
Later we switched to Fermentrack software.
These chambers are used for making beer at 18-21 or 4. Or for making garums 60 C.
Started cultures of mushroom are grown at 30 degrees, see later for more information.

The beginning of Fermentation Station

The fridge wall

The electric wiring

The 60 degrees "fridge" with garums
For meats, cheeses and mushrooms there is need for humidity control.
I made the humidifiers myself, see link, and programmed the Arduinos, see Github.
The meats or sausages can be dried with or without microbe layer.

Meat drying with healthy coat of bacteria

Cheese
To use the by product of brewing, spent grain, I wanted to try cultivating mushrooms.
Therefore, we needed a Laminar flow hood to work sterile.
We made it ourself and its working great.
See picture, I small piece of the inside of an Oyster mushroom was cut out and plated out on Potato Dextrose Agar. Next step is to cut it up in piece, put in sterile spent grain glass pot. More on this process will come.

DIY Laminar flow hood

Oyster mushroom growing on a plate